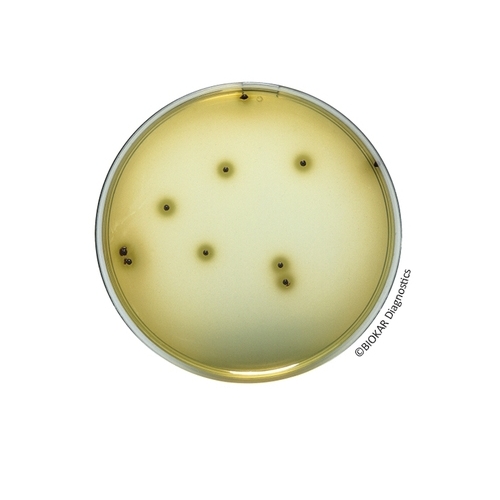

Bismuth Sulfite Agar (ISO 6579-1)
Bismuth Sulfite Agar ISO 6579-1 is a selective medium used to isolate Salmonella in water, dairy products and other food products. This medium is particularly used for the detection of Salmonella enterica subspecies enterica serovars Typhi and Paratyphi in human consumption and the feeding of animals, environmental samples and samples from the primary production stage. Bismuth Sulfite agar can be used in the normalized methods for Salmonella detection as the second isolation media. The typical composition corresponds to that defined in the standards NF EN ISO 6579-1.
| Ürün Adı | Bismuth Sulfite Agar (ISO 6579-1) |
| Ürün Kodu | BK223HA |
| Miktar | 500 g |